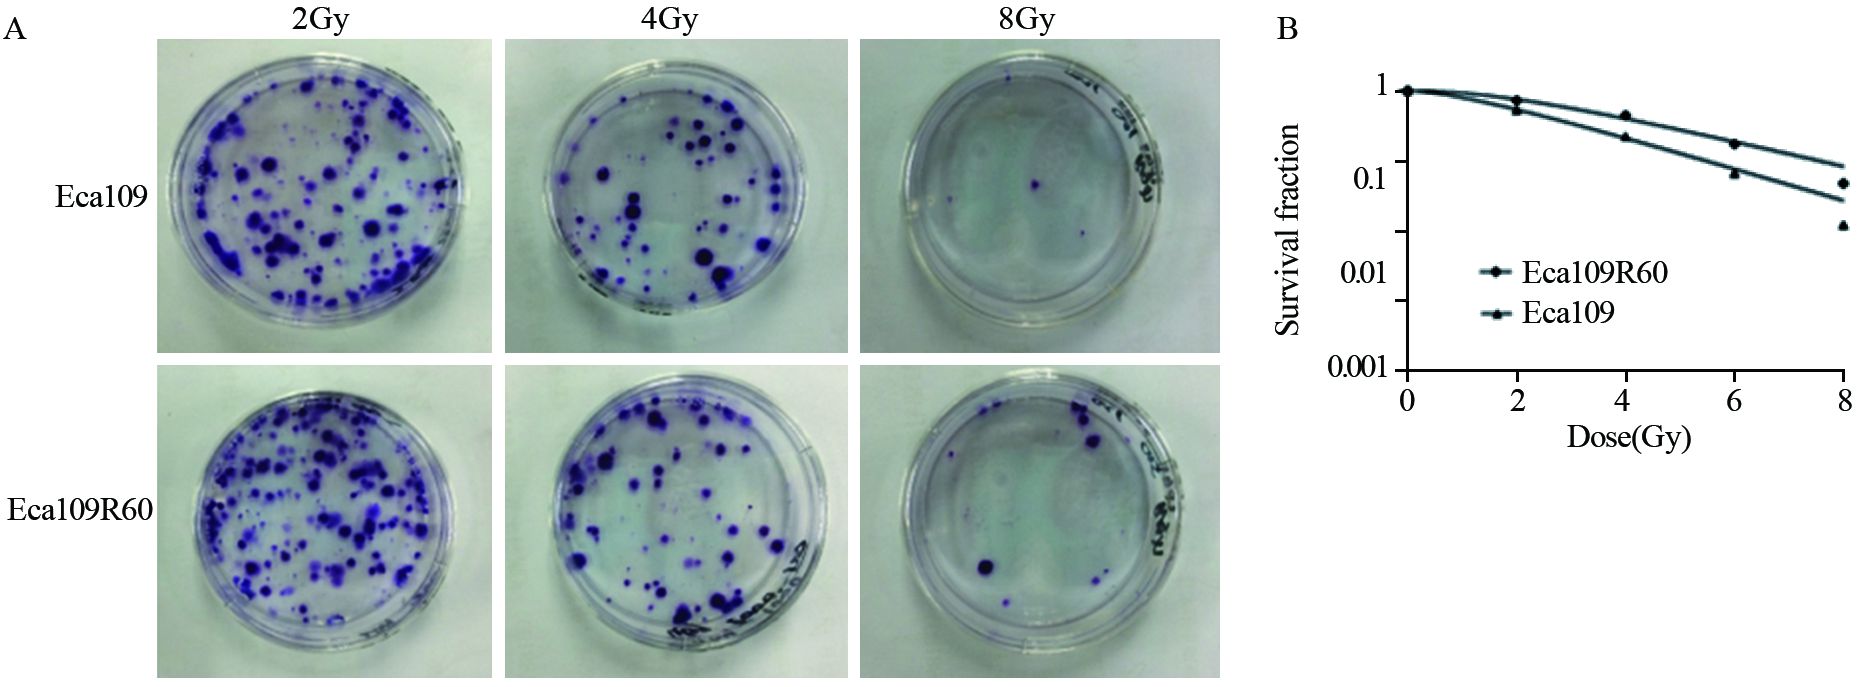

文章信息
- NF-κB与放射线诱导的人食管癌细胞上皮间质转化的关系
- Relationship Between NF-κB and Epithelial-to-mesenchymal Transition of Radiation-induced Human Esophageal Carcinoma Cells
- 肿瘤防治研究, 2016, 43(11): 921-925
- Cancer Research on Prevention and Treatment, 2016, 43(11): 921-925
- http://www.zlfzyj.com/CN/10.3971/j.issn.1000-8578.2016.11.001
- 收稿日期: 2015-12-08
- 修回日期: 2016-03-14
食管癌是全球恶性肿瘤之一,我国是食管癌的高发区[1]。和手术一样,放疗是食管癌的主要根治手段之一。然而,虽然放疗设备和技术发展迅速,使食管癌放疗的靶区和剂量更精准,但其疗效并未随之得到显著提升,局部复发仍然是治疗失败的主要原因,提示食管癌的放射抵抗性是放疗疗效的主要影响因素,因此,揭示食管癌放射抵抗性的形成机制,明确影响放射敏感度的分子靶点,从分子水平提高食管癌的放射敏感度是改善食管癌治疗效果的关键。
Theys等[2]报道,放射线可诱导细胞上皮间质转化(epithelial-to-mesenchymal transition,EMT),通过激活多种信号通路参与肿瘤放射抵抗性的形成,但食管癌放射抵抗性是否与之有关报道较少。许多研究已证实NF-κB信号通路的激活与多种细胞放射抵抗性的形成有密切联系[3-5],其参与食管癌放射抵抗性形成是否与EMT途径有关,目前尚未见报道。本研究拟从获得了放射抵抗性的食管癌细胞入手,研究其NF-κB的表达与肿瘤细胞发生EMT及放射抵抗性的关系,为食管癌放疗疗效的提高提供新的分子靶点,从而为食管癌放疗的精准治疗提供新思路。
1 材料与方法 1.1 细胞系与试剂人食管癌细胞系Eca109由河北医科大学第四医院肿瘤研究中心惠赠。细胞培养所需的RPMI 1640培养液、胰蛋白酶、EDTA等购于北京Solarbio公司,胎牛血清购于澳大利亚Biological Industries公司;Real-time PCR所需相关试剂PrimeScript 1st strand cDNA Synthesis Kit及DBI SYBR Green qPCR master mix购于日本TaKaRa生物公司;免疫细胞化学所需的DAB染色试剂盒、NF-κB p65多克隆抗体、E-cadherin多克隆抗体、Vimentin多克隆抗体等购于北京中杉金桥生物技术有限公司。
1.2 细胞培养将细胞置于含10%胎牛血清,100 u/ml青霉素、100 μg/ml链霉素的RPMI 1640培养液中,在37℃、5%CO2饱和湿度的培养箱中培养,并用0.02%EDTA和0.25%Trysin对处于对数生长期的单层细胞进行消化,并常规分离成单细胞悬液,进行相关实验。
1.3 细胞照射及形态观察、放射抵抗性的测定取对数生长期的人食管癌细胞Eca109,采用Eleketa synergy直线加速器6 MV X线,分次照射不同剂量,由2 Gy开始,依次给予 4、6、8及4次10 Gy照射,累计剂量60 Gy,得到Eca109R60,进行常规培养。
在Leica倒置相差显微镜下,观察照射不同剂量点时食管癌细胞Eca109的形态学变化。应用克隆形成实验比较细胞Eca109和Eca109R60的放射抵抗性。设定0、2、4、6、8 和10 Gy共6个剂量点,给予X线照射,每个计量点设三个平行样,常规培养箱中静止培养直至培养皿中出现肉眼可见的克隆即终止培养。应用克隆形成实验法计算存活分数,利用单击多靶模型拟合细胞生存曲线及放射生物学参数。具体公式如下:集落形成率(PE)=形成集落数/种植细胞数,存活分数(SF)=实验组集落形成率/对照组集落形成率,利用单击多靶模型S=1-(1-e-D/D0) N计算D0、Dq、N和SF2(即照射2 Gy后细胞存活分数)等多个放射生物学参数。
1.4 EMT相关指标及NF-κB检测 1.4.1 Real-time PCRTRIzol法提取细胞总mRNA,荧光定量PCR仪Stratagene Mx3005P进行实时定量PCR检测,以hGAPDH作为参照基因,结果均用ΔΔCt法计算,测定EMT相关指标:上皮细胞标志物E-钙黏蛋白(E-cadherin)和间质细胞标志物波形蛋白(Vimentin)及NF-κB的表达差异。
1.4.2 免疫细胞化学应用免疫细胞化学的方法测定EMT相关指标(E-cadherin,Vimentin)及NF-κB p65的差异。
判断标准如下:染色强度(a)与阳性细胞百分比(b)的乘积综合判断。其中染色强度(a):淡黄色=1分,黄色=2分,棕黄色=3分;阳性细胞所占的百分比(b):≤5%=0分,5%~25%=1分,>25%~50%=2分,>50%~75%=3分,>75%=4分。免疫反应积分(IRS)标准:0分(-);1~4分为(+);6~8分为(++);9~12分为(+++)。
1.5 统计学方法所有统计学处理均采用SPSS13.0统计软件。两组比较采用χ2、t检验或Wilcoxon符号秩检验,采用直线相关或直线回归的方法分析三者之间的关系,检验水准α=0.05,P≤0.05为差异有统计学意义。
2 结果 2.1 放射线诱导EMT与人食管癌上皮细胞Eca109相比,Eca109R60细胞的形态更加不规则,呈细长的纺锤体形、极性消失,细胞之间更加疏松。细胞传代时胰酶消化时间变短,提示细胞黏附性降低,Eca109R60细胞已具备了EMT样表型,见图 1。

|
| 图 1 Eca109与Eca109R60细胞的形态观察 Figure 1 Morphology of Eca109 and Eca109R60 cells |
采用单击多靶模型拟合细胞存活曲线,见图 2,计算出放射生物学参数D0、Dq、N及SF2。Eca109R60细胞的D0、Dq和N值与亲代细胞Eca109相比均增大,见表 1。随着照射剂量的增大,Eca109细胞较Eca109R60细胞存活分数有较大幅度的降低。2 Gy时存活分数SF2是代表细胞放射敏感度的重要指标,SF2越大,放射抗拒性越强,Eca109R60细胞的SF2值高于亲代细胞Eca109,这提示Eca109R60细胞较其亲本更具有放射抵抗性,见表 1。
|
| A: The monoclone cells of Eca109 and Eca109R60 cells tested by Colony-forming assay after irradiated with different doses; B: The survival curves of Eca109 and Eca109R60 cells 图 2 Eca109与Eca109R60细胞放射抵抗性的比较 Figure 2 Comparison of radio-resistance between Eca109 and Eca109R60 cells |
Real-time PCR结果显示,与未经照射的细胞Eca109相比,Eca109R60细胞中E-cadherin基因mRNA的表达明显降低;Vimentin及NF-κB基因mRNA的表达明显上调,见图 3。Eca109R60细胞中NF-κB与E-cadherin基因表达的直线相关系数γ=-0.825(P=0.043),即NF-κB与E-cadherin基因表达呈负相关,NF-κB与Vimentin基因的表达未见明显相关性(γ=0.457,P=0.363),但已显示出正相关的趋势。免疫细胞化学结果显示,与未经照射过的Eca109细胞相比,Eca109R60细胞中E-cadherin阳性染色程度明显降低,Vimentin及NF-κBp65蛋白阳性染色程度增强,见图 4。

|
| 图 3 Eca109与Eca109R60细胞中E-cadherin mRNA、Vimentin mRNA及NF-κB mRNA的表达 Figure 3 Expression of E-cadherin mRNA,Vimentin mRNA and NF-κB mRNA in Eca109 and Eca109R60 cells |

|
| 图 4 Eca109与Eca109R60细胞中E-cadherin、Vimentin及NF-κBp65蛋白的表达 (×400) Figure 4 Expression of E-cadherin,Vimentin and NF-κBp65 protein in Eca109 and Eca109R60 cells(×400) |
食管癌是我国最常见的消化道恶性肿瘤之一,严重威胁我国人民的身体健康和生活质量。我国平均每年死于食管癌的患者高达15万人,其死亡率在所有恶性肿瘤中排名第4位[6]。
肿瘤细胞经放射线反复照射后,平均致死剂量D0及准阈剂量Dq值明显增大(即造成细胞指数性死亡所需的剂量变大),且细胞生长及侵袭力明显增强,即肿瘤细胞产生放射抵抗性。这些衡量放射抵抗性的参数(D0、Dq、N、SF2)能够较真实全面地反映细胞的放射生物学特性,已经被广泛应用于细胞放射抵抗性分析。本实验对食管癌细胞系Eca109反复照射后,D0是其亲本细胞的1.20倍,Dq是其亲本细胞的2.33倍,这与Che等[7]的研究中放射抗拒细胞D0(Eca109R50是亲本细胞的1.43倍)和Dq(Eca109R50是亲本细胞的1.67倍)增高的幅度比较接近。另外,N值与SF2的增大,均提示经过反复照射累积剂量至60 Gy获得的Eca109R60细胞,较其亲本细胞更具放射抵抗性。单击多靶模型拟合的细胞存活曲线显示,随着放射剂量的增大,Eca109较Eca109R60细胞存活率有较大幅度降低,进一步证明食管癌细胞Eca109R60具有更强放射抵抗能力的特性。
EMT是指上皮来源的细胞逐渐失去上皮细胞特性获得间质细胞特性的过程,是一个最基本的生物进程,同时与肿瘤的发生、侵袭和转移有着密切联系[8]。除此之外,许多研究表明,EMT样表型与肿瘤放射抵抗性紧密相关,肿瘤放射抵抗性的产生与细胞发生上皮-间质转化有关[9-10],Tsukamoto等[9]首次证实X射线导致子宫内膜癌细胞发生EMT并使该细胞的侵袭迁移能力增加,敲除Twist( EMT的关键转移因子)可降低射线照射诱导子宫内膜癌细胞侵袭的能力。Su等[10]的研究发现其建立的放射抗拒细胞株KYSE150R呈现出EMT的特点,并伴随有Cyclin D1的过表达。抑制Cyclin D1表达后可以部分逆转EMT表型且降低抗性细胞KYSE150R的放射抵抗性。本实验结果显示经放射线照射后的食管癌上皮细胞Eca109R60在形态学上呈现出长梭形、纺锤体状、不规则、极性消失,且细胞间的黏附性降低,传代时胰酶消化时间变短,提示该细胞具有EMT的表型。Real-time PCR和免疫细胞化学显示EMT上皮标志物E-cadherin表达下调,间质标志物Vimentin表达上调,这进一步表明经放射线照射后Eca109R60细胞发生了EMT。
EMT是上皮细胞来源的恶性肿瘤细胞获得迁移和侵袭能力的重要生物学过程。多数研究均证实放射线照射引起细胞发生EMT后,通过激活多种信号通路诱导肿瘤细胞放射抵抗性的形成。目前的研究显示,NF-κB信号通路与肿瘤细胞放射抗性关系较为明确[11-15]。另有研究认为,肺癌和乳腺癌细胞发生EMT后可通过NF-κB信号通路参与肿瘤的侵袭和转移[16-17]。由此推测,放射线照射诱导食管癌细胞发生EMT后有可能通过NF-κB信号通路参与放射抵抗性的形成。
石磊等研究发现,胰腺癌细胞NF-κB的激活可以促进Vimentin的表达,同时抑制E-cadherin的表达[18],与本研究结果相似。Yan等也发现NF-κB的活化可以使大肠癌细胞整合素连接激酶(ILK)过表达,促使细胞发生EMT[19]。但目前NF-κB促使细胞发生EMT的作用是否与放射抵抗性形成有关报道较少。
本研究对EMT相关标志物检测后发现,在经过反复照射获得的细胞Eca109R60中,上皮标志物E-cadherin表达下调,间质标志物Vimentin表达上调,进一步证实放射线照射可诱导肿瘤细胞发生EMT。此外,NF-κB在Eca109R60细胞中mRNA及蛋白水平表达均上调,相关性分析显示,其表达与E-cadherin成明显负相关,提示放射线照射诱导食管癌细胞发生EMT后NF-κB通路可能参与放射抵抗性的形成,但详细机制尚需进一步研究。
综上,经过累积照射的食管癌细胞Eca109R60放射线照射之后,发生了上皮间质转化,有可能通过激活NF-κB信号通路,参与抵抗性形成,这为提高食管癌放射敏感度提供了新的方向和依据。
| [1] | Stewart BW, Wild C. World Cancer Report 2014[M]. Lyon: The International Agency for Research on Cancer, 2014 : 529 -30. |
| [2] | Theys J, Jutten B, Habets R, et al. E-cadherin loss associated with EMT promotes radioresistance in human tumor cells[J]. Radiother Oncol, 2011, 99 (3) : 392–7. DOI:10.1016/j.radonc.2011.05.044 |
| [3] | Lan F, Yue X, Ren G, et al. miR-15a/16 enhances radiation sensitivity of non-small cell lung cancer cells by targeting the TLR1/NF-κB signaling pathway[J]. Int J Radiat Oncol Biol Phys, 2015, 91 (1) : 73–81. DOI:10.1016/j.ijrobp.2014.09.021 |
| [4] | Zhang Y, Wei Y, Zhu Z, et al. Icariin enhances radiosensitivity of colorectal cancer cells by suppressing NF-κB activity[J]. Cell Biochem Biophys, 2014, 69 (2) : 303–10. DOI:10.1007/s12013-013-9799-x |
| [5] | Ahmed KM, Zhang H, Park CC. NF-κB regulates radioresistance mediated by β1-integrin in three-dimensional culture of breast cancer cells[J]. Cancer Res, 2013, 73 (12) : 3737–48. DOI:10.1158/0008-5472.CAN-12-3537 |
| [6] | Yin J, Li T. Individual comprehensive therapy study for esophageal carinoma[J]. Guo Ji Zhong Liu Xue Za Zhi, 2012, 39 (7) : 526–9. [ 阴骏, 李涛. 食管癌个体化综合治疗的研究[J]. 国际肿瘤学杂志, 2012, 39 (7) : 526–9. ] |
| [7] | Che SM, Zhang XZ, Liu XL, et al. The radiosensitization effect of NS398 on esophageal cancer stem cell-like radioresistant cells[J]. Dis Esophagus, 2011, 24 (4) : 265–73. DOI:10.1111/j.1442-2050.2010.01138.x |
| [8] | Li WW, Zhang LL, Hu GQ. Effect of transcription factor snail on invasion and migration of esophageal carcinoma cell line Eca-109[J]. Zhong Liu Fang Zhi Yan Jiu, 2015, 42 (4) : 319–23. [ 李文雯, 张琳丽, 胡国清. 转录因子Snail对食管癌Eca-109细胞侵袭和迁移的影响[J]. 肿瘤防治研究, 2015, 42 (4) : 319–23. ] |
| [9] | Tsukamoto H, Shibata K, Kajiyama H, et al. Irradiation-induced epithelial-mesenchymal transition (EMT) related to invasive potential in endometrial carcinoma cells[J]. Gynecol Oncol, 2007, 107 (3) : 500–4. DOI:10.1016/j.ygyno.2007.08.058 |
| [10] | Su H, Jin X, Shen L, et al. Inhibition of cyclin D1 enhances sensitivity to radiotherapy and reverses epithelial to mesenchymal transition for esophageal cancer cells[J]. Tumour Biol, 2016, 37 (4) : 5355–63. DOI:10.1007/s13277-015-4393-z |
| [11] | Meyn RE, Milas L, Ang KK. The role of apoptosis in radiation oncology[J]. Int J Radiat Biol, 2009, 85 (2) : 107–15. DOI:10.1080/09553000802662595 |
| [12] | Bhat KP, Balasubramaniyan V, Vaillant B, et al. Mesenchymal differentiation mediated by NF-κB promotes radiation resistance in glioblastoma[J]. Cancer Cell, 2013, 24 (3) : 331–46. DOI:10.1016/j.ccr.2013.08.001 |
| [13] | Xue XY, Liu ZH, Jing FM, et al. Relationship between NRAGE and the radioresistance of esophageal carcinoma cell line TE13R120[J]. Chin J Cancer, 2010, 29 (10) : 900–6. DOI:10.5732/cjc.010.10141 |
| [14] | Duru N, Candas D, Jiang G, et al. Breast cancer adaptive resistance: HER2 and cancer stem cell repopulation in a heterogeneous tumor society[J]. J Cancer Res Clin Oncol, 2014, 140 (1) : 1–14. DOI:10.1007/s00432-013-1494-1 |
| [15] | Sinha S, Ghildiyal R, Mehta VS, et al. ATM-NFκB axis-driven TIGAR regulates sensitivity of glioma cells to radiomimetics in the presence of TNFα[J]. Cell Death Dis, 2013, 4 : e615. DOI:10.1038/cddis.2013.128 |
| [16] | Sun Q, Yao X, Ning Y, et al. Overexpression of response gene to complement 32(RGC32) promotes cell invasion and induces epithelial-mesenchymal transition in lung cancer cells via the NF-κB signaling pathway[J]. Tumour Biol, 2013, 34 (5) : 2995–3002. DOI:10.1007/s13277-013-0864-2 |
| [17] | Huber MA, Azoitei N, Baumann B, et al. NF-kappaB is essential for epithelial-mesenchymal transition and metastasis in a model of breast cancer progression[J]. J Clin Invest, 2004, 114 (4) : 569–81. DOI:10.1172/JCI200421358 |
| [18] | Shi L, Wang SM, He JF. Expression of NF-κB and its relation with epithelial-mesenchymal transition in pancreatic cancer[J]. Zhong Liu Yan Jiu Yu Lin Chuang, 2011, 23 (3) : 191–3. [ 石磊, 王世明, 贺杰峰. 核转录因子-κB在胰腺癌中的表达及其与上皮细胞间质转化的关系[J]. 肿瘤研究与临床, 2011, 23 (3) : 191–3. ] |
| [19] | Yan Z, Yin H, Wang R, et al. Overexpression of integrin-linked kinase (ILK) promotes migration and invasion of colorectal cancer cells by inducing epithelial-mesenchymal transition via NF-κB signaling[J]. Acta Histochem, 2014, 116 (3) : 527–33. DOI:10.1016/j.acthis.2013.11.001 |
 2016, Vol. 43
2016, Vol. 43



